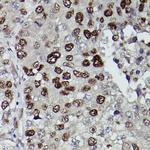
JMJD1A Antibody in Immunohistochemistry (Paraffin) (IHC (P))

Search
Invitrogen
JMJD1A Polyclonal Antibody
{{$productOrderCtrl.translations['antibody.pdp.commerceCard.promotion.promotions']}}
{{$productOrderCtrl.translations['antibody.pdp.commerceCard.promotion.viewpromo']}}
{{$productOrderCtrl.translations['antibody.pdp.commerceCard.promotion.promocode']}}: {{promo.promoCode}} {{promo.promoTitle}} {{promo.promoDescription}}. {{$productOrderCtrl.translations['antibody.pdp.commerceCard.promotion.learnmore']}}
图: 1 / 5
JMJD1A Antibody (PA5-88279) in ICC/IF

Please note: We are reviewing Western blot images included in the antibody testing data in our catalog, including those provided by third parties. Unless expressly labeled or annotated as “raw-unedited”, Western blot images included in the antibody testing data in our catalog may have been edited, optimized or otherwise adjusted for presentation.
产品信息
PA5-88279
种属反应
已发表种属
宿主/亚型
分类
类型
抗原
偶联物
形式
浓度
规格
纯化类型
保存液
内含物
保存条件
运输条件
RRID
产品详细信息
Positive Samples: 293T; Cellular Location: Cytoplasm, Nucleus
Immunogen sequence: PVMVSGVHHK LNSELWKPES FRKEFGEQEV DLVNCRTNEI ITGATVGDFW DGFEDVPNRL KNEKEPMVLK LKDWPPGEDF RDMMPSRFDD LMANIPLPEY TRRDGKLNLA SRLPNYFVRP DLGPKMYNAY GLITPEDRKY GTTNLHLDVS DAANVMVYVG IPKGQCEQEE EVLKTIQDGD SDELTIKRFI EGKEKPGALW HIYAAKDTEK IREFLKKVSE EQGQENPADH DPIHDQSWYL DRSLRKRLHQ EYGVQGWAIV QFLGDVVFIP AGAPHQVHNL YSCIKVAEDF VSPEHVKHCF WLTQEFRYL
靶标信息
JMJD1A is a histone demethylase that specifically demethylates 'Lys-9' of histone H3, thereby playing a central role in histone code. It preferentially demethylates mono- and dimethylated H3 'Lys-9' residue, with a preference for dimethylated residue, while it has weak or no activity on trimethylated H3 'Lys-9'. Demethylation of Lys residue generates formaldehyde and succinate. JMJD1A is involved in hormone-dependent transcriptional activation, by participating in recruitment to androgen-receptor target genes, resulting in H3 'Lys-9' demethylation and transcriptional activation. It's also Involved in spermatogenesis by regulating expression of target genes such as PRM1 and TMP1 which are required for packaging and condensation of sperm chromatin. Involved in obesity resistance through regulation of metabolic genes such as PPARA and UCP1.
仅用于科研。不用于诊断过程。未经明确授权不得转售。
生物信息学
蛋白别名: DKFZp686A24246; DKFZp686P07111




